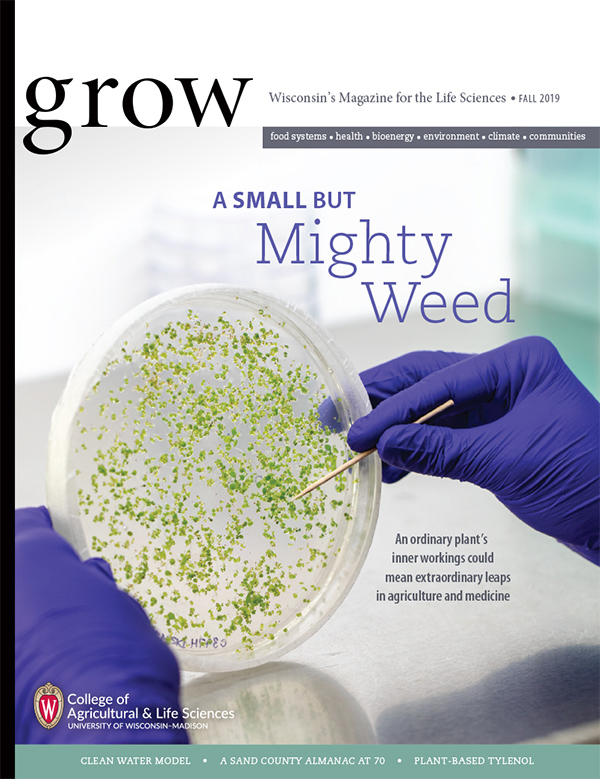

Plant epigenetics, water quality, big data and more: The fall issue of Grow is now in mailboxes and inboxes
The fall issue of Grow magazine is out in print and live on the web. Feature stories include:
The fall issue of Grow magazine is out in print and live on the web. Feature stories include:
- COVER STORY: Deep in the Weeds | Close study of an ordinary plant’s cellular mechanisms could lead to big advances in agriculture and medicine. Read more.
- A Model Solution | Researchers expand a powerful computer simulation tool to study and address nitrate contamination in Wisconsin’s groundwater. Read more.
- Big Data Wranglers | From computer vision to cloud computing, CALS scientists are finding ways to gather and analyze massive amounts of information for better farm management. Read more.
Other topics include the 70th anniversary of A Sandy County Almanac, award-winning student-made cookies, pain meds made from poplar, bioacoustics and conservation in tropical forests, potato and vegetable crop protection, and more.
And don’t forget the Final Exam. Can you ace the test for a chance to win a box of cheese from Babcock Hall? Good luck!

